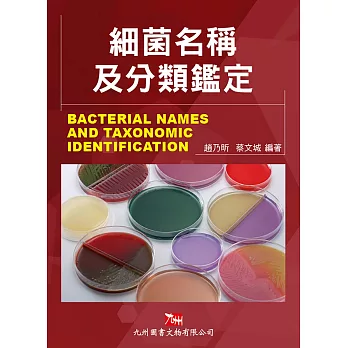
細菌名稱及分類鑑定

|
售價:333  |
| 搜尋參考資料: 1.健康促進理論與實務(第三版) | 大專教科書、高中職教科 … www.wun-ching.com.tw/book_detail.asp?seq=2281Translate this page 健康促進理論與實務(第三版) 出版日:2015/1/5 ; 書號:b155e3; 作者:張蓓貞; isbn:978-986-236-970-8 ; 總頁數:312; 開數 / 印刷 ... ejournal.stpi.narl.org.tw/NSC_INDEX/Journal/EJ0001/10102/10102-09.pdf 一 般 報 導 58 |科學發展 2012年2月,470期 李美慧 環境荷爾蒙與 嬰幼兒健康 過去十多年來,每年都會看到許多令人擔心,且 ... https://zh.wikipedia.org/zh-tw/國際健康功能與身心障礙...Translate this page 國際健康功能與身心障礙分類( 英語: International Classification of Functioning, Disability, and Health ,簡稱 ICF ),這項健康分類系統 ... www.coa.gov.tw/view.php?catid=13826Translate this page 全球環境與農業面臨之挑戰 (歷史期刊資料,內容僅供參考) sites.cjcu.edu.tw/efsTranslate this page 長榮大學環境與食品安全檢驗學士學位學程 . 一、學程沿革. 食品安全與國人健康息息相關,台灣因部分業者而使社會大眾對 ... |
詳細資料ISBN:9789861943497 規格:平裝 / 368頁 / 17 X 23 CM / 普通級/ 單色印刷 / 二版 出版地:台灣 內容簡介 透過本書之介紹,讀者應能從第1章《緒論》開始體認到人類與環境的關係;從各章專論如第2章《水汙染與健康》、第3章《空氣汙染與健康》、第4章《廢棄物汙染與健康》、第5章《噪音汙染與健康》、第6章《食品與健康》、第7章《病媒與健康》、第8章《輻射能量與健康》、第9章《職業環境與健康》與第10章《生活環境衛生與健康》中,了解各環境問題的現況與因應之道;最後經由第11章《環境變遷、保育與永續》,省思我們應如何保護環境,學習與自然共存,使自己與後代生活在健康、安全的環境中。 本版新增的內容如下:「夜市觀光垃圾處理」、「災後飲用水注意事項」、「台肥銨氣外洩」、「高雄氣爆事件」、「重金屬廢棄物回收」、「噪音及過動兒」、「福島核災之健康風險評估」、「熱危害防護」、「過勞之定義、成因與預防管理」、「有效的生態監測」、「鞭炮及煙火釋放」、「溫室氣體公報」等,期使讀者對整體環境健康問題有更深、更完整的了解。 本書利用淺顯的詞句、條列的說明,使得艱深難懂的環境領域議題變得簡明易懂本書特色 1.專有名詞:黑體標示並於各章最後做解釋,協助理解內容。 2.相關時事專欄:使學理與生活接軌,快速掌握社會最新的脈動。 3.章節架構圖:方便內容查詢,一目了然。 4.課後練習:選擇題與問答題,檢視學習成效更多元。 |
還有去各大拍賣網站RUTEN露天、YAHOO拍賣收集商品資料!最近有些網友在問環境與健康(2版)要去哪裡買最便宜呢?當今網購市場很競爭,各大購物網為求好業績無所不用其極,殺價毫不手軟。RYAN也嘗試積極推荐,並介紹我該商品優缺點。RYAN也請我幫忙收集該商品資料! |
最近我也在找環境與健康(2版)的相關資訊~到實際到銷售的EC去看,價格就有機會再便宜一些!整理資訊大致有分享文、開箱文、試用文、評鑑文、推薦文、是否便宜、優缺點等資訊.環境與健康(2版)數量有限,售完為止!限量是殘酷的,不要猶豫入手要快~最近有些網友在問環境與健康(2版)要去哪裡買最便宜呢? |
#熱銷商品#
|
資料來源:博客來
限會員,要發表迴響,請先登入